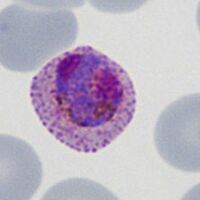
B

Navigation
>Main Malaria Index
>>Malaria Biology Index
>>>Biology of the schizont
>>>Current page: Morphology of Schizonts
How does schizont appearance change during their development?
Schizonts formation involves successive cycles of asexual division that eventually result in the formation of multiple separate "merozoite" forms. Those merozoites are released as the red cell breaks down then go on to infect another red cell. Schizonts therefre look very different depending on which stage of development they represent. Below are images of schizonts at different developmental stages.
THE INITIAL ASEXUAL DIVISION
The first recognisable stage occurs when the schizonts first divide their chromatin to form two distinct masses. This first stage is the least distinctive and can be difficult to distinguish from a late trophozoite or gametocyte with a double chromatin dot. But often the appearance is clear.
The cartoon image (A) shows the division of chromatin into two distinct purple chromatin masses within the blue parasite cytoplasm (at this point the cytoplams is not divided so indiviual merozoites are not really distinguishable). A clinical image of a parasite at this developmental stage (P.ovale with well shown James'dots) is shown in panel (B).
IMMATURE SCHIZONT APPEARANCES
As schizont development proceeds further cycles of division cause the appearance of mutiple separate areas chromatin that will eventually form the merozoies, although at this stage they still lie within a single cytoplasmic mass. The number of divisions varies between species, so in mature schizonts this can contribute to species identification (see schizont gallery). Note that as the parasites develop the haemoglobin is metabolised so the red cell becomes more pale, and the products of red cell breakdown (malaria pigment) become more prominent.
The cartoon image (A) shows the further division of chromatin (Chr) into many discrete massed within the blue parasite cytoplasm (Cy). Indiviual merozoites are still not distinguishable but the malaria pigment is obvious (Pi). A clinical image of a parasite at this developmental stage (again from P.ovale with well shown James'dots and malaria pigment) is shown in panel (B).
MATURE SCHIZONT APPEARANCES
By this stage the individual merozoites can be distinguished, each with a chromatin dot and cytoplasm; they are now ready for release from the red cell.
The asexual division cycles are now complete cartoon image (A) shows the merozoites (M) as discrete chromatin with blue cytoplasm. Malaria pigment is present (P). The clinical image of a parasite at this developmental stage (again from P.ovale with well shown James'dots and malaria pigment) is shown in panel (B).
MEROZOITE RELEASE
In the final stage the red cell membrane is broken down, swelling then separating to release the merozoites and any malaria pigment into the blood where each merozoite enters a red cell to form a new early trophozoite and increasing the infection load.
Merozoites cause the red cell membrane to be expanded then to break down; the merozoites (M) are now clearly separate and move apart, the pigment (P) is also released during this process (A); this is shown in the clinical image (B) although this brief stage is rarely seen in practice (P.malariae).
|